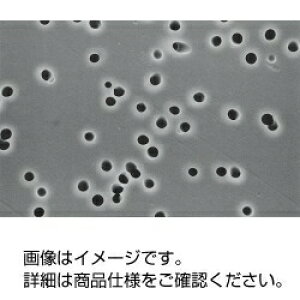
|J[{l[g^Cv utB^ K020A047A@3-314-0176

「A047」の人気商品一覧 | 安い商品を通販サイトから探す
282件 121〜160件を表示- 価格の安い順
- 価格の高い順
- 検索条件:
- 計測用具
- 本ページでは掲載するECサイトやメーカー等から購入実績などに基づいて手数料を受領しています。
![■SIBATA メンブレンフィルター A100A047A 100入〔品番:064300047100〕【1123009:0】[送料別途見積り][掲外取寄][店頭受取不可]](https://tshop.r10s.jp/hcvalor-eshop/cabinet/trusco/1123/trusco-1123009.jpg?fitin=300:300)
その他の計測用具
《メーカー》柴田科学(株)《品番》064300-047100《特長》●液体や気体の中に含まれる微生物や微粒子を取り除くことができますので、電子、製薬、食品、医学、理化学など、きわめて幅広い分野でご利用いただけます。●各種試験分野から製
この商品で絞り込む

その他の計測用具
【アズワン AS ONE】汎用器具・消耗品 保護・手袋・ウエア2 一般手袋 ●ニトリルゴムをコーティングしているため、油や突き刺し、引っ掻きに強く、耐摩耗性に優れています。 ●背抜きコーティングのため手にピッタリとフィットし、通気性
この商品で絞り込む
![■SIBATA メンブレンフィルター A300A047A 100入 064300047300(1126192)[送料別途見積り][法人・事業所限定][掲外取寄]](https://tshop.r10s.jp/first23/cabinet/trusco/1126/trusco-1126192.jpg?fitin=300:300)
その他の計測用具
オレンジブック トラスコ中山 TRUSCOSIBATA メンブレンフィルター A300A047A 100入 〔品番:064300047300〕[ 注番:1126192]特長●液体や気体の中に含まれる微...
この商品で絞り込む

その他の計測用具
重量分析や微生物試験に適しています。130℃まで安定しており、オートクレーブ(125℃)も可能です。※オートクレーブ、エチレンオキサイドガス(EOG)による数回の滅菌が可能です。
![■SIBATA メンブレンフィルター H100A047A 100入 064410047100(1126234)[送料別途見積り][法人・事業所限定][掲外取寄]](https://tshop.r10s.jp/first23/cabinet/trusco/1126/trusco-1126234.jpg?fitin=300:300)
その他の計測用具
オレンジブック トラスコ中山 TRUSCOSIBATA メンブレンフィルター H100A047A 100入 〔品番:064410047100〕[ 注番:1126234]特長●液体や気体の中に含まれる微生物や微粒子を取り除くことができる...
![■SIBATA メンブレンフィルター H020A047A 100入 064410047020(1124614)[送料別途見積り][法人・事業所限定][掲外取寄]](https://tshop.r10s.jp/first23/cabinet/trusco/1124/trusco-1124614.jpg?fitin=300:300)
その他の計測用具
オレンジブック トラスコ中山 TRUSCOSIBATA メンブレンフィルター H020A047A 100入 〔品番:064410047020〕[ 注番:1124614]特長●液体や気体の中に含まれる微...
この商品で絞り込む
![■SIBATA メンブレンフィルター C020A047A 100入 064320047020(1121504)[送料別途見積り][法人・事業所限定][掲外取寄]](https://tshop.r10s.jp/first23/cabinet/trusco/1121/trusco-1121504.jpg?fitin=300:300)
その他の計測用具
オレンジブック トラスコ中山 TRUSCOSIBATA メンブレンフィルター C020A047A 100入 〔品番:064320047020〕[ 注番:1121504]特長●液体や気体の中に含まれる微...
この商品で絞り込む
![■SIBATA メンブレンフィルター H050A047A 100入〔品番:064410047050〕【1121521:0】[送料別途見積り][掲外取寄][店頭受取不可]](https://tshop.r10s.jp/hcvalor-eshop/cabinet/trusco/1121/trusco-1121521.jpg?fitin=300:300)
その他の計測用具
《メーカー》柴田科学(株)《品番》064410-047050《特長》●液体や気体の中に含まれる微生物や微粒子を取り除くことができる為、電子、製薬、食品、医学、理化学など、きわめて幅広い分野でご利用いただけます。●PTFEメンブレンフィルタ
この商品で絞り込む

その他の計測用具
大口割引も受付中!お問い合わせください。TEL:045-243-0716 ■メンブレンフィルター A080A047A 100入 064300-047080 の特長 ●液体や気体の中に含まれる微生...
この商品で絞り込む
この商品で絞り込む

その他の計測用具
大口割引も受付中!お問い合わせください。TEL:045-243-0716 ■メンブレンフィルター A045A047A 100入 064300-047045 の特長 ●液体や気体の中に含まれる微生...
この商品で絞り込む

その他の計測用具
【アズワン AS ONE】汎用器具・消耗品 保護・手袋・ウエア2 一般手袋 ●ニトリルゴムをコーティングしているため、油や突き刺し、引っ掻きに強く、耐摩耗性に優れています。 ●背抜きコーティングのため手にピッタリとフィットし、通気性
この商品で絞り込む
![■SIBATA メンブレンフィルター H100A047A 100入 064410047100(1126234)[送料別途見積り][法人・事業所限定][掲外取寄]](https://tshop.r10s.jp/first34/cabinet/1126/trusco-1126234.jpg?fitin=300:300)
その他の計測用具
オレンジブック トラスコ中山 TRUSCOSIBATA メンブレンフィルター H100A047A 100入 〔品番:064410047100〕[ 注番:1126234]特長●液体や気体の中に含まれる微...
この商品で絞り込む
![■SIBATA メンブレンフィルター H020A047A 100入 064410047020(1124614)[送料別途見積り][法人・事業所限定][掲外取寄]](https://tshop.r10s.jp/first34/cabinet/1124/trusco-1124614.jpg?fitin=300:300)
その他の計測用具
オレンジブック トラスコ中山 TRUSCOSIBATA メンブレンフィルター H020A047A 100入 〔品番:064410047020〕[ 注番:1124614]特長●液体や気体の中に含まれる微生物や微粒子を取り除くことができる...

その他の計測用具
セルロース混合エステルタイプ(白色、無地)特長:主に水系の粒子除去、濾過滅菌用として用いられます。品目:メンブレンフィルターA500A孔径:5.00μm直径(mm):47入数(枚):100記載品のほか、微生物、微粒子試験用として罫線入...
![アズワン AS ONE メンブレンフィルタT010A047A百枚 4-871-03 [1445-0101131]](https://tshop.r10s.jp/daishinshop/cabinet/item/1445-118/1445-0101131.jpg?fitin=300:300)
その他の計測用具
納期目安 (メーカーに在庫がある場合)13:30までにご注文の場合約3〜7日後出荷(土日祝日を除く)※表示の納期目安はあくまで目安ですのでお約束ではありません。具体的納期は都度お問い合わせください。お取り寄せ品です!ご注文後[商

その他の計測用具
特長 ●液体や気体の中に含まれる微生物や微粒子を取り除くことができますので、電子、製薬、食品、医学、理化学など、きわめて幅広い分野でご利用いただけます。 ●各種試験分野から製薬、飲料、醸造、化学などの工業ろ過分野に至る
この商品で絞り込む

その他の計測用具
重量分析や微生物試験に適しています。130℃まで安定しており、オートクレーブ(125℃)も可能です。※オートクレーブ、エチレンオキサイドガス(EOG)による数回の滅菌が可能です。
![アズワン AS ONE メンブレンフィルタA010A047A百枚 4-877-03 [1445-0101073]](https://tshop.r10s.jp/daishinshop/cabinet/item/1445-118/1445-0101073.jpg?fitin=300:300)
その他の計測用具
納期目安 (メーカーに在庫がある場合)13:30までにご注文の場合約3〜7日後出荷(土日祝日を除く)※表示の納期目安はあくまで目安ですのでお約束ではありません。具体的納期は都度お問い合わせください。お取り寄せ品です!ご注文後[商

その他の計測用具
重量分析や微生物試験に適しています。130℃まで安定しており、オートクレーブ(125℃)も可能です。※オートクレーブ、エチレンオキサイドガス(EOG)による数回の滅菌が可能です。
![■SIBATA メンブレンフィルター H050A047A 100入 064410047050(1121521)[送料別途見積り][法人・事業所限定][掲外取寄]](https://tshop.r10s.jp/first23/cabinet/trusco/1121/trusco-1121521.jpg?fitin=300:300)
その他の計測用具
オレンジブック トラスコ中山 TRUSCOSIBATA メンブレンフィルター H050A047A 100入 〔品番:064410047050〕[ 注番:1121521]特長●液体や気体の中に含まれる微...
この商品で絞り込む
![■SIBATA メンブレンフィルター A010A047A 100入 064300047010(1124652)[送料別途見積り][法人・事業所限定][掲外取寄]](https://tshop.r10s.jp/first23/cabinet/trusco/1124/trusco-1124652.jpg?fitin=300:300)
その他の計測用具
オレンジブック トラスコ中山 TRUSCOSIBATA メンブレンフィルター A010A047A 100入 〔品番:064300047010〕[ 注番:1124652]特長●液体や気体の中に含まれる微...
この商品で絞り込む
その他の計測用具
均一な表示径の円筒状孔を持つフィルタで、捕捉物の走査型電子顕微鏡観察や液体中・気体中の微粒子計数に適しています。

その他の計測用具
【アズワン AS ONE】分析・特殊機器 検査用品 微生物検査用品 ●ポリエステル不織布が基材に入っているため、取り扱いやすくオートクレーブ滅菌・エチレンオキサイドガス滅菌や乾熱滅菌(180℃)にも耐えます。 ●材質が不活性なため、蛋白質
この商品で絞り込む

その他の計測用具
型番C020A047A (100枚) 商品説明●タンパク質等の吸着が少なく、セルロース混合エステルメンブレンフィルタに比べ、アルコール類に耐性があるフィルタです。 ●孔径 0.20μm ●直径 47mmφ...

その他の計測用具
特長 ●液体や気体の中に含まれる微生物や微粒子を取り除くことができますので、電子、製薬、食品、医学、理化学など、きわめて幅広い分野でご利用いただけます。 ●各種試験分野から製薬、飲料、醸造、化学などの工業ろ過分野に至る
この商品で絞り込む

その他の計測用具
重量分析や微生物試験に適しています。130℃まで安定しており、オートクレーブ(125℃)も可能です。※オートクレーブ、エチレンオキサイドガス(EOG)による数回の滅菌が可能です。
![■SIBATA メンブレンフィルター H100A047A 100入 064410047100(1126234)[送料別途見積り][法人・事業所限定][掲外取寄]](https://tshop.r10s.jp/first23/cabinet/trusco/1126/trusco-1126234.jpg?fitin=300:300)
その他の計測用具
オレンジブック トラスコ中山 TRUSCOSIBATA メンブレンフィルター H100A047A 100入 〔品番:064410047100〕[ 注番:1126234]特長●液体や気体の中に含まれる微...
この商品で絞り込む

その他の計測用具
特長 ●液体や気体の中に含まれる微生物や微粒子を取り除くことができますので、電子、製薬、食品、医学、理化学など、きわめて幅広い分野でご利用いただけます。 ●各種試験分野から製薬、飲料、醸造、化学などの工業ろ過分野に至る
この商品で絞り込む

その他の計測用具
セルロース混合エステルタイプ(白色、無地)特長:主に水系の粒子除去、濾過滅菌用として用いられます。品目:メンブレンフィルターA045A孔径:0.45μm直径(mm):47入数(枚):100記載品のほか、微生物、微粒子試験用として罫線入...
この商品で絞り込む

その他の計測用具
【画像はイメージです】発送日が表示納期を超える場合は、別途ご相談いたします。★数量・大口割引も受付中!お問い合わせください。TEL:045-243-0716 ■メンブレンフィルター C300A047A 100入 064320-0473...
![アズワン AS ONE メンブレンフィルタA045F047A百枚 4-909-09 [1445-0101039]](https://tshop.r10s.jp/daishinshop/cabinet/item/1445-118/1445-0101039.jpg?fitin=300:300)
その他の計測用具
納期目安 (メーカーに在庫がある場合)13:30までにご注文の場合約3〜7日後出荷(土日祝日を除く)※表示の納期目安はあくまで目安ですのでお約束ではありません。具体的納期は都度お問い合わせください。お取り寄せ品です!ご注文後[商

その他の計測用具
型番H020A047A (100枚) 商品説明●PTFEメンブレンフィルタに親水性処理を施しています。 ●水系・有機系溶剤共に使えるメンブレンフィルタです。 ●孔径 0.20μm ●直径 47mmφ ...
この商品で絞り込む
![■SIBATA メンブレンフィルター A080A047A 100入〔品番:064300047080〕【1121517:0】[送料別途見積り][掲外取寄][店頭受取不可]](https://tshop.r10s.jp/hcvalor-eshop/cabinet/trusco/1121/trusco-1121517.jpg?fitin=300:300)
その他の計測用具
《メーカー》柴田科学(株)《品番》064300-047080《特長》●液体や気体の中に含まれる微生物や微粒子を取り除くことができますので、電子、製薬、食品、医学、理化学など、きわめて幅広い分野でご利用いただけます。●各種試験分野から製
この商品で絞り込む

その他の計測用具
TDK 積層セラミックコンデンサ(MLCC) 100V dc 0.047μF ±10% 1袋(50個入)●TDK Cタイプ0603シリーズ●TDKの業務用Cシリーズの業務用積層セラミックチップコンデンサ製品です。低ESR特性と優れた周...
![■SIBATA メンブレンフィルター A080A047A 100入 064300047080(1121517)[送料別途見積り][法人・事業所限定][掲外取寄]](https://tshop.r10s.jp/first23/cabinet/trusco/1121/trusco-1121517.jpg?fitin=300:300)
その他の計測用具
オレンジブック トラスコ中山 TRUSCOSIBATA メンブレンフィルター A080A047A 100入 〔品番:064300047080〕[ 注番:1121517]特長●液体や気体の中に含まれる微生物や微粒子を取り除くことができま...
その他の計測用具カテゴリで検索されているキーワード:
お探しの商品はみつかりましたか?
検索条件の変更
ご利用前にお読み下さい
- ※ ご購入の前には必ずショップで最新情報をご確認下さい
- ※ 「掲載情報のご利用にあたって」を必ずご確認ください
- ※ 掲載している価格やスペック・付属品・画像など全ての情報は、万全の保証をいたしかねます。あらかじめご了承ください。
- ※ 各ショップの価格や在庫状況は常に変動しています。購入を検討する場合は、最新の情報を必ずご確認下さい。
- ※ ご購入の前には必ずショップのWebサイトで価格・利用規定等をご確認下さい。
- ※ 掲載しているスペック情報は万全な保証をいたしかねます。実際に購入を検討する場合は、必ず各メーカーへご確認ください。
- ※ ご購入の前にネット通販の注意点をご一読ください。
- ※ 本ページでは掲載するECサイトやメーカー等から購入実績などに基づいて手数料を受領しています。
- A047
- DIY・工具
- 計測用具の通販情報・価格比較
- 価格.com
© Kakaku.com, Inc. All Rights Reserved. 無断転載禁止







